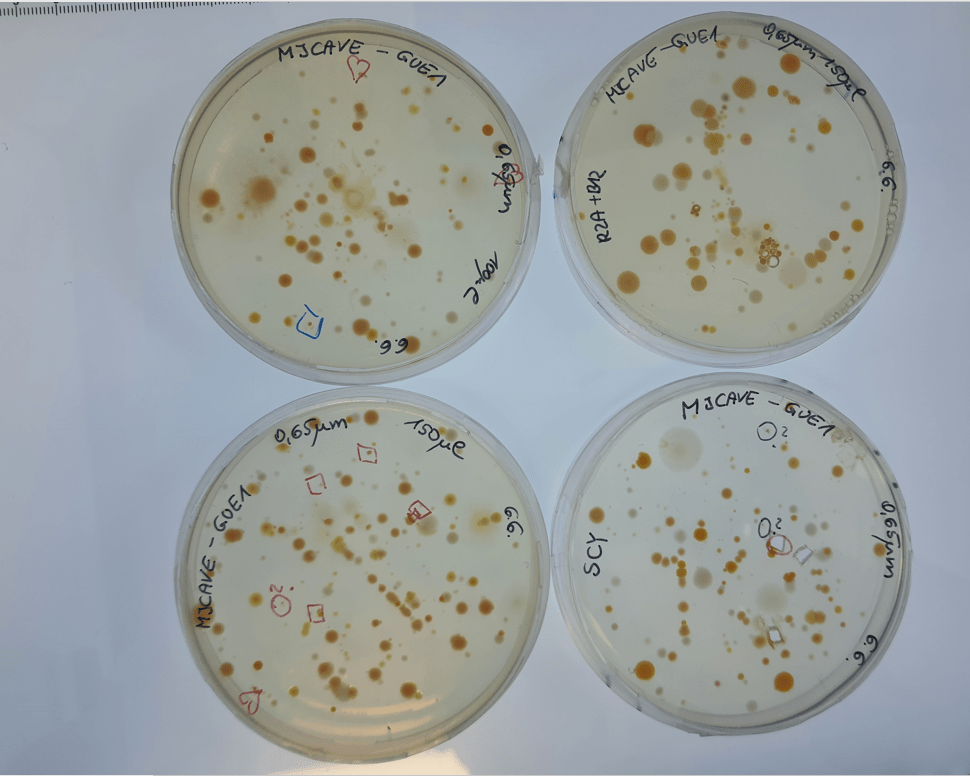
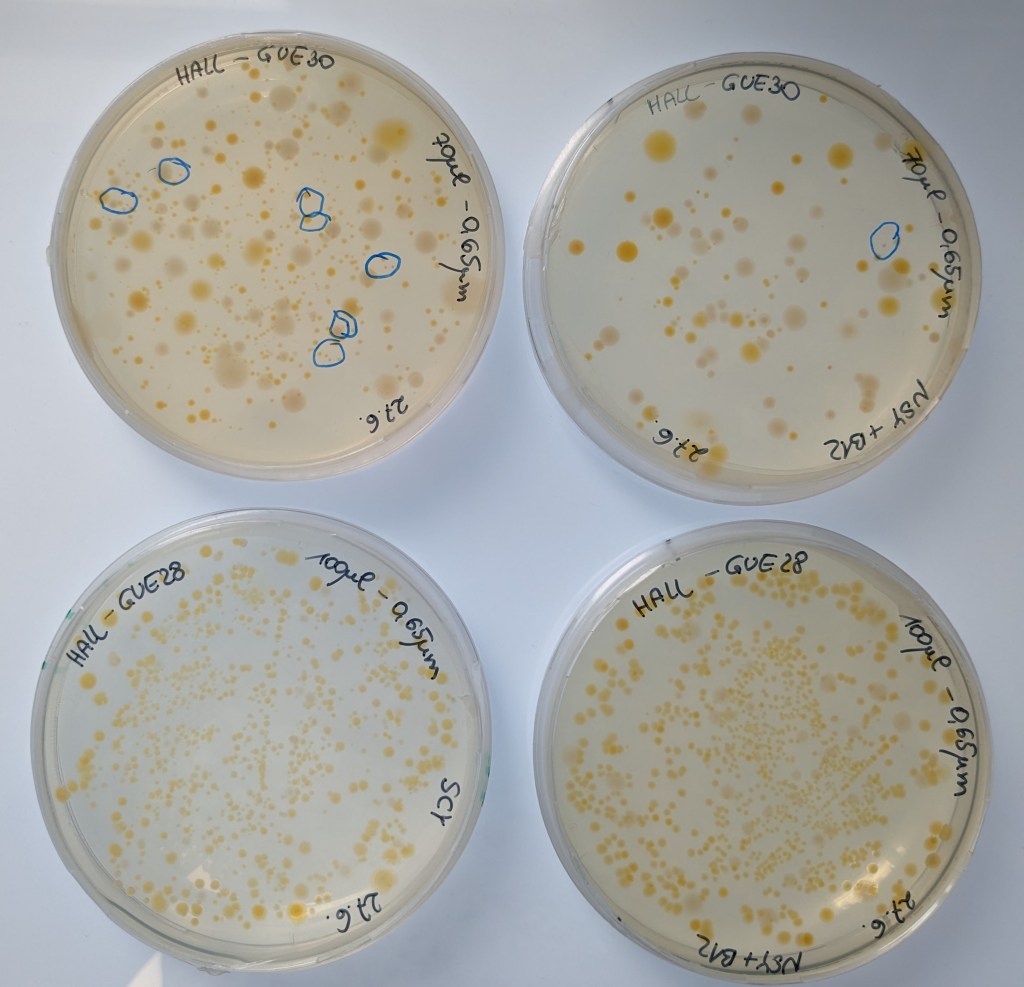
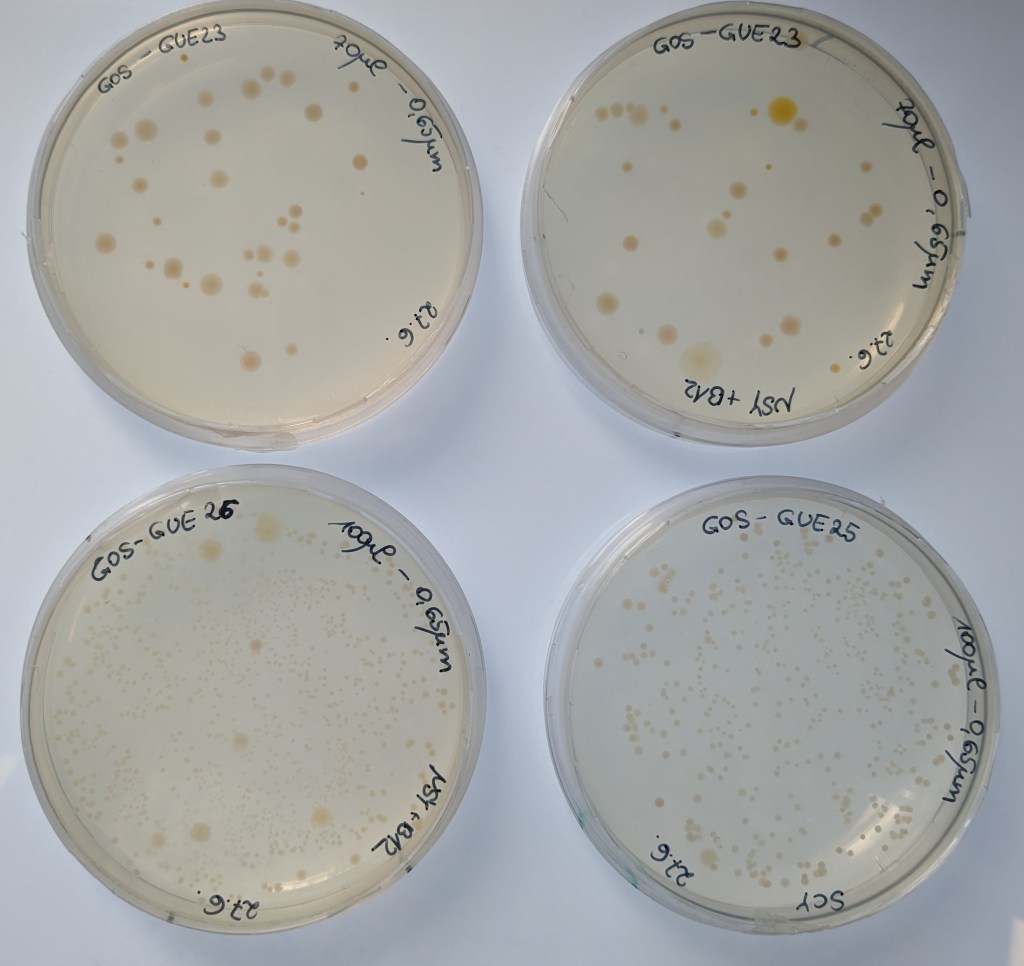

Taucher nehmen Wasserproben bei ihren Tauchgängen

Wir freuen und sehr, dass Taucher der GUE Austria nun am Projekt teilnehmen. Sie werden bei ihren Tauchgängen für uns Wasserproben nehmen. Da wir bis jetzt noch keinen Hinweis auf unsere Aquirufa Bakterien in größeren Wassertiefen haben, sind wir schon sehr gespannt auf die Ergebnisse.
1. Zu Besuch am Institut in Mondsee
Am 16.6.2023 hatten wir unsere erste Veranstaltung in unserem Forschungsinstitut am Mondsee. Sabrina Pitt hatte im Rahmen einer Lehrveranstaltung der PH Salzburg zum Workshop ‚Forschung trifft Gesellschaft‘ eingeladen. zum ganzen Beitrag

2. Höhlen in Bukarest
Lukas Moravec hat uns von einem Tauchgang in Höhlen in Budapest Wasserproben mitgebracht. Unsere Aquirufa Bakterien konnten wir zwar bis jetzt noch nicht finden, aber eine ganze Reihe anderer typische Gewässerbakterien. Mit Hilfe von Sequenzierung des 16S rRNA Gens haben wir zum Beispiel identifizieren können: Brevundimonas albigilva sowie eine noch unentdeckte weitere Art von Brevundimonas, Caulobacter mirabilis, Daejeonella lutea.
Und so sehen die mit dem Höhlenwasser beimpften Agarplatten aus (man sieht an den Markierungen, dass wir damit gearbeitet haben 😉 )
3. Gosausee und Hallstätter See
Florian Wolff hat uns aus dem Gosausee und aus dem Hallstättersee Proben von Tauchgängen mitgebracht. Wir haben die Wasserproben filtriert und dann verschiedene Agarplatten damit beimpft. Auf den Agarplatten vom Hallstättersee haben wir schon interessante rote Kolonien entdeckt, man sieht es an den blauen Markierungen.

4. Die Bakterienarten im Hallstättersee
Aus der Wasserprobe von Florian Wolff konnten wir Bakterienkulturen von zwei Aquirufa Arten isolieren. Eine ist die weite verbreite Art Aquirufa antheringensis, die andere die neu entdeckte Art aus dem Leopoldskronerweiher. Das ist sehr interessant und wir werden den Hallstättersee in unser weiteres Untersuchungsprogramm aufnehmen. Darin werden wir der Diversität von Aquirufa direkt aus Wasserproben, ohne Gewinnung von Bakterienkulturen, auf den Grund gehen.

5. Probenahme unter Wasser: Film von Lisa und Lukas Moravec
6. Erste Publikation erschienen
Unsere erste wissenschaftliche Publikation im Projekt ist erschienen und hier verfügbar.
Sie enthält die Beschreibung einer neuen Bakterienart aus dem Leopoldskroner Weiher. Sie ist eine wirkliche Gemeinschaftsarbeit. Unsere Kooperationspartner von der DSMZ Braunschweig und den GUE Austria sowie Schülerinnen und Schüler vom BORG Nonntal, dem BG Vöcklabruck und dem BRG Schloss Wagrain haben mitgewirkt. Alle sind in der Danksagung namentlich erwähnt. Ganz ❤️ lichen Dank 😊.

7. Tauchgang am Hallstätter See

Heute waren wir zu einer besonderen Probenahme unterwegs. Fünf Taucher von unserem Kooperationspartner GUE Austria hatten sich mit uns am Hallstätter See verabredet. zum ganzen Beitrag
8. Neue Proben zum Kultivieren von Bakterien
Von Maik Westreicher haben wir Proben aus Feldkirchen an der Donau von den Teichen dort bekommen. Ausserdem haben wir noch eine Wasserprobe aus dem ‚Kessel‘, einer Höhle am Hallstätter See von einem Tauchgang mit Lukas Moravec erhalten. Damit werden wir nochmal versuchen Bakterienkulturen von unserer gesuchten Gattung Aquirufa zu bekommen.
9. Wissenschaftliche Publikation erschienen
Unsere 3. wissenschaftliche Publikation ist erschienen und hier online verfügbar. Ca. 130 Citizen Scientist haben dabei mitgewirkt. Sechs Schulklassen und weitere Citizen Scientists haben Wasserproben aus selbst gewählten Gewässern genommen…hier gehts zum Beitrag



